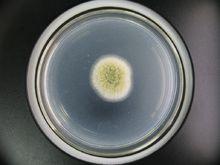
米麴黴蛋白酶

定義
米麴黴蛋白酶
米麴黴蛋白酶米麴黴蛋白酶種類繁多,目前已做檢測的米麴黴蛋白酶包括 9 種酸性蛋白酶,3 種中性蛋白酶,6 種鹼性蛋白酶。目前,在食品上套用比較廣泛的產蛋白酶安全菌株主要有枯草芽孢桿菌,黑麴黴和米麴黴。其中米麴黴是一類產複合酶的菌株,主要產蛋白酶、澱粉酶、糖化酶、纖維素酶、植酸酶等,作為最重要的酶製劑而廣泛使用。米麴黴蛋白酶在發酵豆製品的生產過程中起著舉足輕重的作用,已套用一千年之久,主要是通過蛋白酶的作用將大分子蛋白質降解為蛋白腖、多肽及各種胺基酸(含有 8 種人體所需的必需胺基酸),提高了大豆的營養價值、保健功效和消化率。在醬油和豆醬發酵過程中,具有很強的蛋白酶合成能力,其蛋白酶在一個比較廣的 pH範圍內都具有活性,而且穩定性高,能耐受較高的溫度,因此廣泛套用。而且米麴黴含有豐富糖苷水解酶將澱粉或纖維素等廉價原料高效生產蛋白酶,所以是食品用蛋白酶的主要來源菌株。
結構
酶的催化性質與酶分子的結構密切相關。特別是酶的三級結構,對酶對催化機制有重大影響,同一種酶,由於高級機構的不同,參與的反應可能就不同。郭繼平等採用結構生物學和生物信息學手段對米麴黴鹼性蛋白酶的三維結構進行了同源模建。通過序列相似性搜尋蛋白序列資料庫和布魯克海文PDB蛋白結構資料庫,找到了編號pdb|2B6N|A和pdb|11C6|A的蛋白質與米麴黴鹼性蛋白酶序列同源性達到了45%和44%。隨後又進行了模體搜尋,結果顯示米麴黴鹼性蛋白酶具有Peptidase_S8結構域。故採用pdb|2B6N|A和pdb|lIC6|A為模板,利用SWISS-MODEL分子模建服務系統模建了米麴黴鹼性蛋白酶三維結構。
基因
趙國忠等對相同培養條件下的不同米麴黴菌株之間進行了比較基因組學和蛋白質組學的研究,分析醬油發酵過程中米麴黴的關鍵基因和蛋白對醬油風味產生的影響。通過米麴黴3.042(中國卿米麴黴RIB40(日本)菌株的基因姐學比較,發現與醬油風味物質形成相關的特異基因。圍繞米麴黴3.042及其誘變菌株米麴黴100-8的蛋白質組學比較,找到米麴黴代謝過程中與風味物質形成有關的蛋白,為醬油工藝的改進提供了理論基礎。常淑君構建米麴黴WB40的全長cDNA表達文庫,初級文庫滴度約為2.96x10 CFU/mL,重組率約為97.8%,插入片段平均長度大於1.5kb,達到一個高質量cDNA文庫的要求。文庫擴增後,滴度達到3.4x10 CFU/mL。對米麴黴基礎生物學研究及相關基因的篩選與克隆奠定了基礎。
催化性質與動力學
 米麴黴蛋白酶
米麴黴蛋白酶中性蛋白酶是米麴黴分泌的重要蛋白酶,目前醬油企業往往以中性蛋白酶的酶活力為指標之一來判斷醬油曲的質量好壞。楊世平等研究了米麴黴中性蛋白酶的特性,指出米麴黴中性蛋白酶的最適反應溫度為55°C,最適反應pH值為7.2,此酶的熱穩定性較好。蔣愛鳳等從白酒大曲中分離純化米麴黴菌種,制大曲後,用生理鹽水提取粗酶液,再用硫酸銨沉澱提取中性蛋白酶,並對其酶學性質進行研究。結果該中性蛋白酶的最適反應溫度為55°C,最適反應pH值為7.0。NaCl和EDTA對該酶具有抑制作用。王棟等米麴黴CICIMF0899和滬釀3.042為研究對象,對2株菌種產蛋白酶的酶學性質進行比較研究,結果思示米麴黴CICIMF0899產的蛋白酶比滬釀3.042更耐高溫、鹽和低pH。
湯鳴強等對米麴黴菌種F-81所產中性蛋白酶進行分離純化,得到一種電泳純的中性蛋白酶,經SDS-PAGE電泳測定其相對分子質量約為73.4KDa。於艷穎等以對米麴黴HDF-7所產蛋白酶進行分離純化,得到一種電泳純的蛋白酶,經SDS-PAGE電泳測定其相對分子質量約為30KDa。由於醬油發酵pH值是在4.5-6偏酸性的環境,因此對酸性蛋白酶的研究也逐漸引起重視。胡穩奇等用水從米麴黴A-9005菌株的款曲培養物中抽提酸性蛋白酶,該酸性蛋白酶的最適作用溫度為50°C,最適pH為3.5-4.7,pH超過6時酶活力迅速喪失。D.Wang等從米麴黴中分離到一種高耐鹽性的中性蛋白酶,並對其酶學性質和動力學特性進行來研究。以特定的底物為目標,研究蛋白酶的催化性能可以從側面米麴黴的發酵性能。張青等研究了在不同底物濃度、溫度和pH條件下米麴黴蛋白酶水解酪蛋白產生酪氨酸的動力學特性。楊遠帆等利用米麴黴能分泌多種蛋白酶的特性,研究該菌培養液水解魚粉的動力學。除了蛋白酶和澱粉酶的研究,對纖維素酶,脂肪酶等也進行了研究。魯梅芳等研究了曲種纖維素酶活力與醬油成分的相關性,結果表明提高醬油生產菌株的纖維素酶活力,可有效的提高發酵醬油的質量,提高原料利用率及出油率。
目前國內對米麴黴蛋白酶的動力學研究報導較少,而動力學研究是了解酶性質的重要方面,因此開展這類研究意義重大。
套用
酸性蛋白酶是烘焙、酒類、皮革等工業的重要用酶。其中,皮革工業主要是利用酸性蛋白酶改變蛋白的內部結構,達到物質間的分離,從而脫毛和軟化,這樣不僅可以提高效率,還可以改善其工作條件;另外,蠶絲的脫膠,肉類的嫩化,酒類的澄清等工作上也能夠使用蛋白酶來達到效果;在醫學上有治療消化不良的胃蛋白酶,治療支氣管炎的酸性蛋白酶等醫療用酶。
中性蛋白酶套用於蛋白水解粉、烘烤行業、大豆分離蛋白、啤酒工業、醫藥、紡織等重要領域。在食品行業中,中性蛋白酶主要是用於食品營養強化劑並生產一些附加值較高的食品,主要原因是它可以將大分子蛋白質分解成小分子的肽或胺基酸,以利於人體的吸收和利用,小分子的肽和胺基酸類形成食品的風味,提高了產品的品質。麵團中添加中性蛋白酶,由於大分子物質水解成小分子物質,其麵團筋力減小,使其有較強的可塑性,在工藝上發揮了巨大的作用。在酒類生產的原料大麥、大豆等植物性蛋白中添加中性蛋白酶,可排除蛋白質產生的"冷混濁"現象,起澄清作用;在醫藥方面,含中性蛋白酶的藥物,可起到消炎、利膽、止痛、助消化的功效。在紡織生產過程中,中性蛋白酶主要用於皮毛的軟化和脫毛,羊毛等皮毛用中性蛋白酶處理後,其抗張度較強,使得毛線手感柔軟,收縮性為0;利用中性蛋白酶製成的脫毛劑,皮革脫毛乾淨、光亮、無損傷。另外,中性蛋白酶還可用於飼料,在飼料中添加中性蛋白酶,有利於提高蛋白質的利用率和降低飼養成本。
鹼性蛋白酶的主要套用領域:洗滌劑、製革、絲綢、飼料、醫藥、食品、環保,其套用主要圍繞其水解蛋白質肽鍵的功能展開,生產生活中,有幾個主要的需求:1. 使複雜的大分子蛋白質結構變成簡單的小分子肽鏈或者胺基酸,從而變得易於吸收或洗去,比如食品、洗滌劑、飼料等領域。其中最常見的是加酶洗衣粉,它是洗滌劑中的新產品,其鹼性蛋白酶的添加能去除衣物上的血漬和蛋白污物;2. 部分破壞蛋白質結構,使物質組分之間實現分離,這在皮革、絲綢等含蛋白質豐富的材料加工時十分有效;3. 促進環境污染物降解,用於環保領域;4. 蛋白酶既能催化水解反應,也能催化其逆反應,而且具備高度的活性和專一性,非常適合醫藥工業對某些特定分子的生產需求,如彈性蛋白酶、胰蛋白酶、胰凝乳蛋白酶。
氨肽酶套用比較廣泛,主要是利用氨肽酶進一步水解蛋白質的酶解液達到脫苦的目的,其中包括亮氨醯氨肽酶、脯氨肽酶,因為肽鏈末端胺基酸殘基除去後,其三維結構會發生顯著改變,對酶解的敏感性增強;劉通訊通過研究發現,用氨肽酶進行二次水解所產生的多肽含量比單一用蛋白酶水解得到的多肽含量能提高將就一成。
羧肽酶主要套用於醫藥、食品中,如前列腺癌的治療;高 F 值寡肽的製備;並用於羧肽酶常與氨肽酶、內肽酶共同作用,套用於食品風味加工,脫苦。

